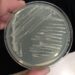
Investigadores describen nueva especie bacteriana

Su llegada permitirá la continuidad y el fortalecimiento de un equipo consolidado y experimentado, en el cual Francisco agregará valor desde su trayectoria profesional de más de 20 años de experiencia ligado a la agroindustria y nutrición animal.
Valdés es Ingeniero Acuícola de la Universidad de Los Lagos y cuenta con un MBA en Administración de Negocios de la Universidad del Desarrollo además de estudios en UCD en Michael Smurfit Graduate Business School, de Dublin, Irlanda.

Ramiro Larios, gerente general de Vitapro Chile, manifestó que la adhesión de Francisco al equipo “permitirá continuar nuestra operación a paso firme, cosechando éxitos, y alcanzando nuevos objetivos. Estamos convencidos de que sus años de experiencia en la gerencia de unidades de negocio en la industria aportarán a la compañía y potenciarán el espíritu de Salmofood.”
Un equipo de expertos acompañará la transición que implica la llegada de Francisco, quien toma la posta de Ernesto Passalacqua, garantizando así la excelencia que caracteriza a Vitapro Chile.
Ernesto está emprendiendo un nuevo rumbo profesional en el desarrollo de proyectos personales. “El constante compromiso y profesionalismo de Ernesto, nos ha permitido crecer junto a nuestros clientes durante 9 años, tiempo en el que hemos construido una sólida operación. Agradecemos todo el trabajo realizado y le deseamos éxito en su nuevo camino”, comenta Larios.
En Vitapro Chile continuamos trabajando para garantizar los estándares de calidad que nos caracterizan, desarrollando productos y soluciones innovadoras de alto valor, fortaleciendo nuestro crecimiento en el país y honrando así la confianza construida durante décadas con nuestros clientes.